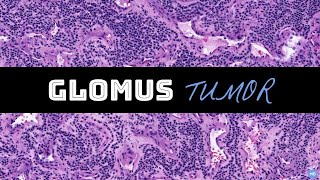

Shared 1 year ago
9.4K views
Shared 11 months ago
2.8K views
Shared 4 months ago
2.9K views
Shared 10 months ago
1.7K views
Shared 2 years ago
8.5K views
Shared 3 years ago
6.9K views
Shared 1 year ago
2.9K views
Shared 1 year ago
1.1K views
Shared 3 years ago
252 views
Shared 3 years ago
355 views
Shared 3 years ago
323 views
Shared 3 years ago
843 views
Shared 2 years ago
331 views
Shared 6 years ago
1.1K views
Shared 6 years ago
65 views
Shared 3 years ago
194 views
Shared 2 years ago
220 views
Shared 2 years ago
345 views
Shared 5 years ago
490 views
Shared 7 years ago
1.3K views
Shared 6 years ago
88 views
Shared 7 years ago
375 views
Shared 6 years ago
1.6K views
Shared 3 years ago
393 views
Shared 2 years ago
74 views